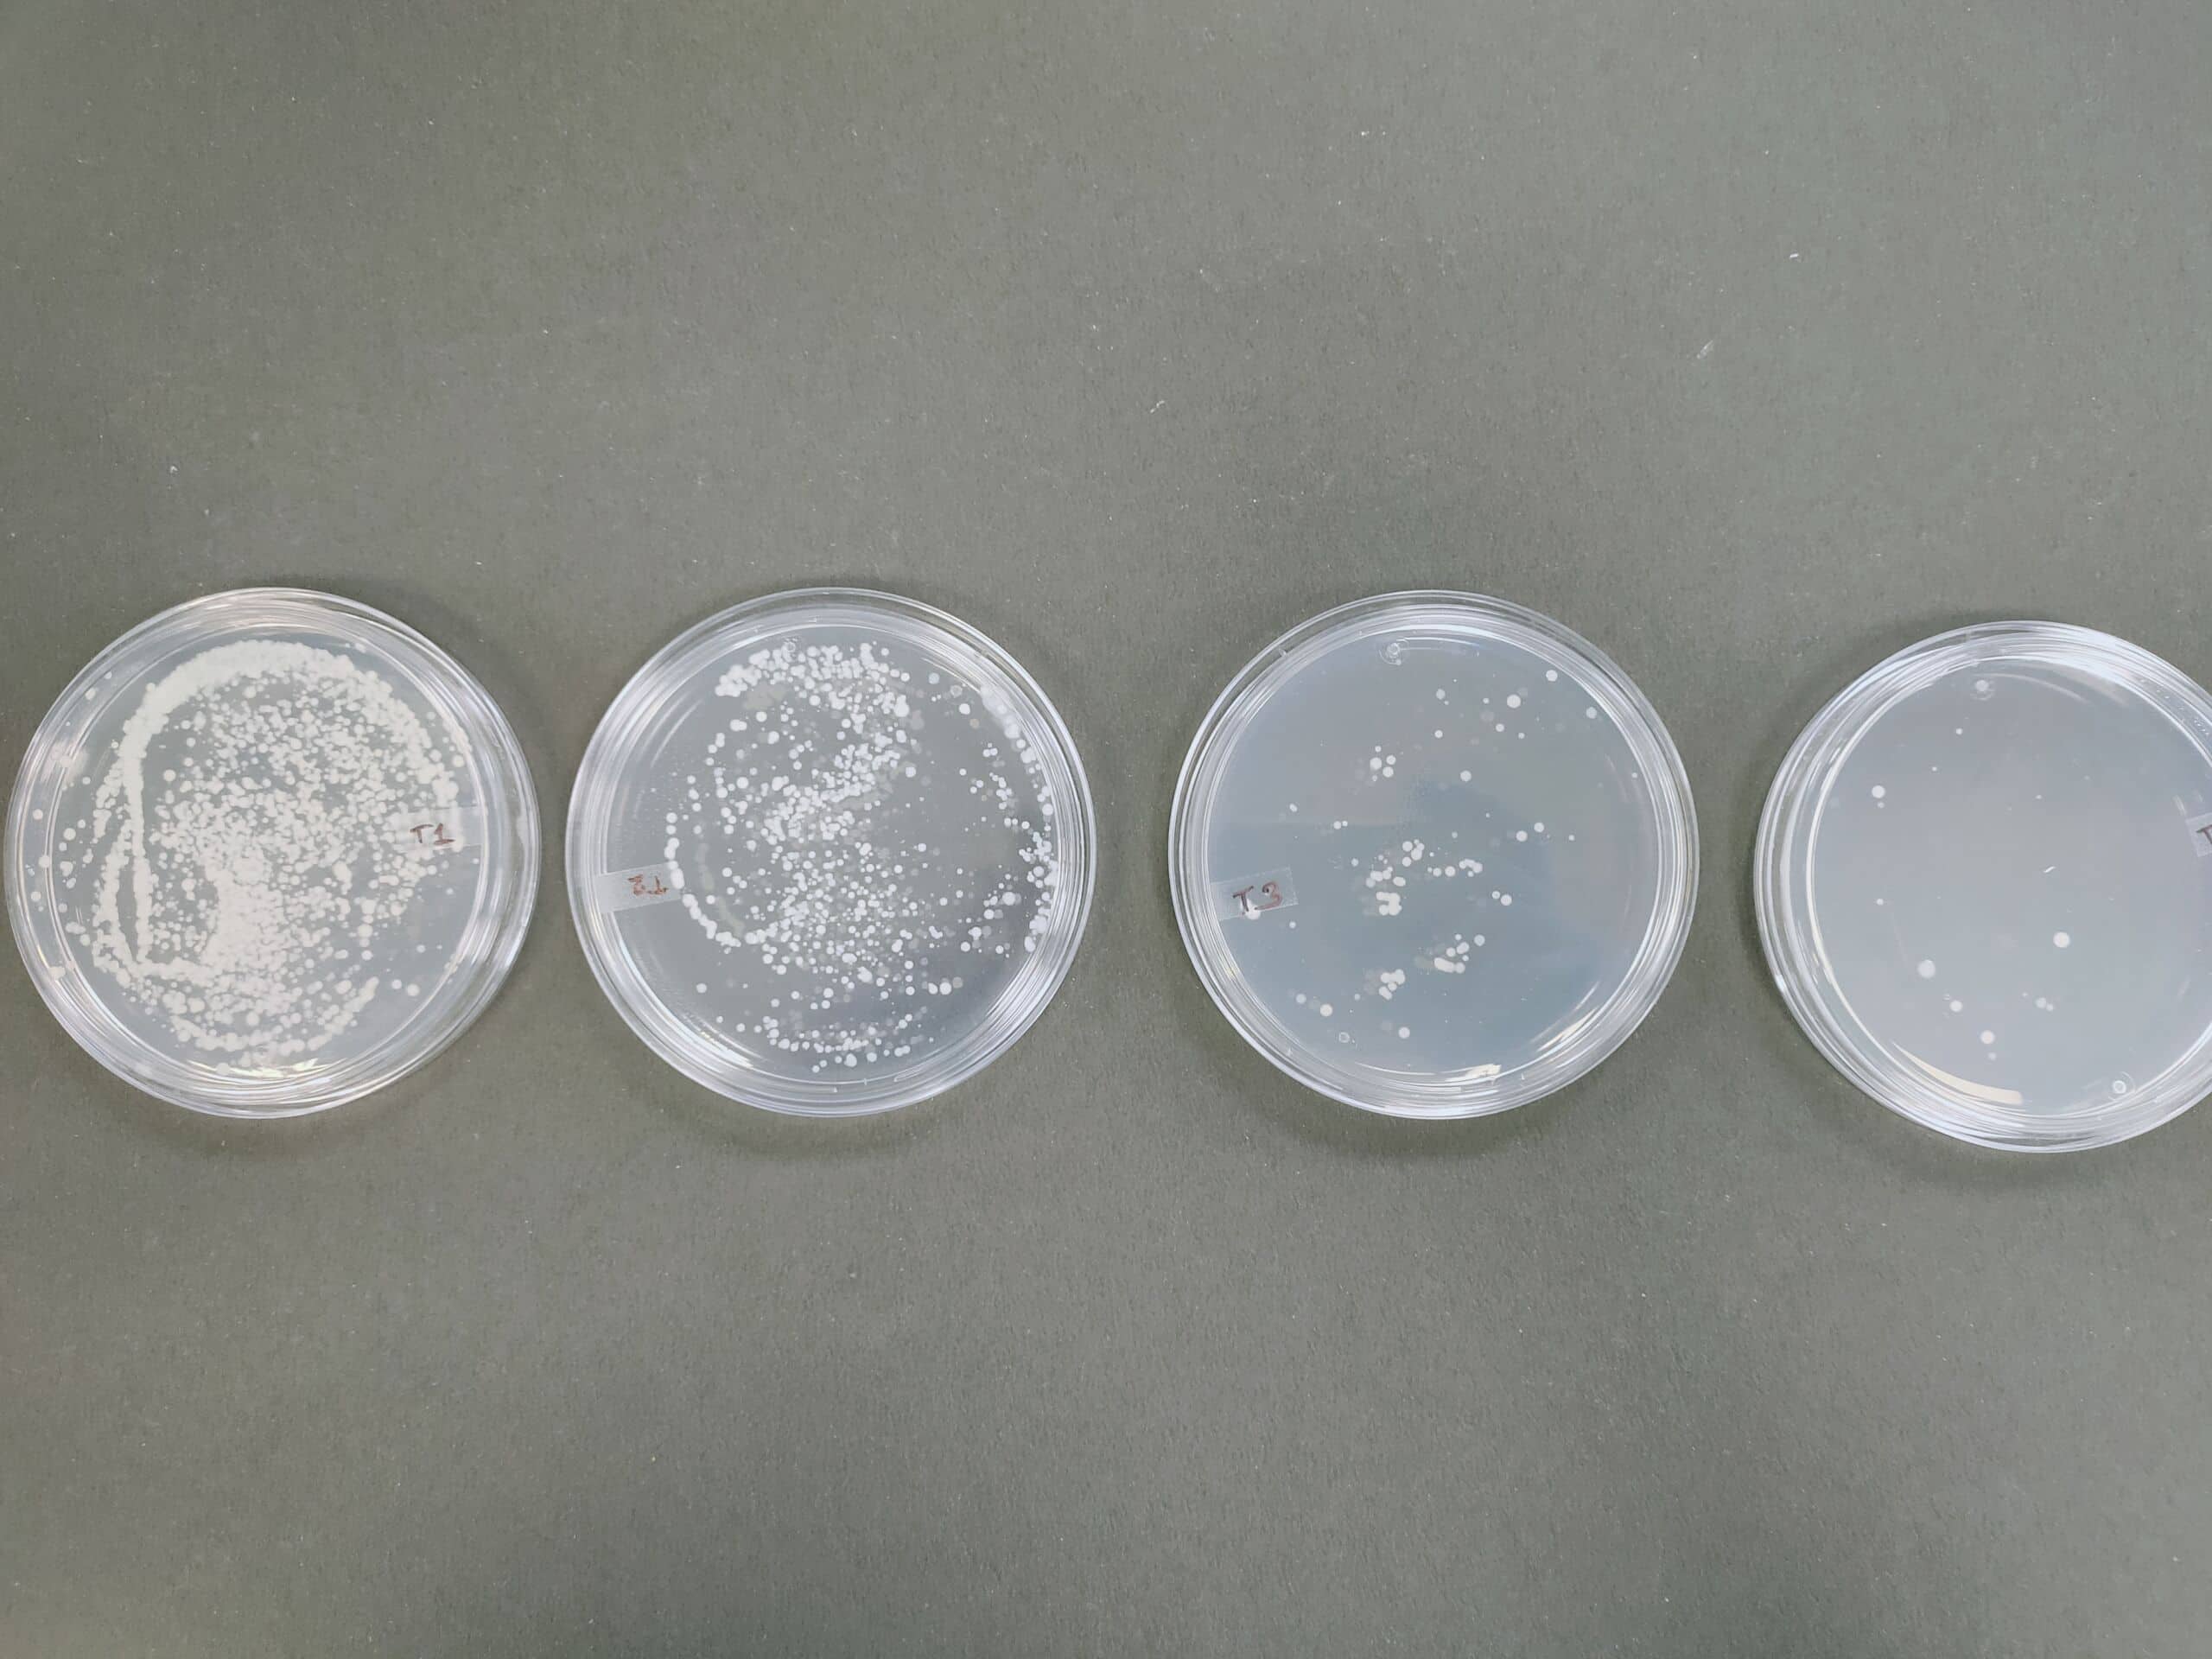
Plasma Wastewater Purification

Indian Institute of Technology Delhi (IITD)

About
The Indian Institute of Technology Delhi (IITD) is one of India's premier engineering and technology institutes, established in 1961. Located in New Delhi, IITD is known for its world-class education, cutting-edge research, and innovation in fields like engineering, computer science, design, and business. As part of the IIT system, IIT Delhi is renowned for its rigorous academic programs, exceptional faculty, and strong industry connections. It produces leaders in technology and entrepreneurship, with a global impact in research and development.